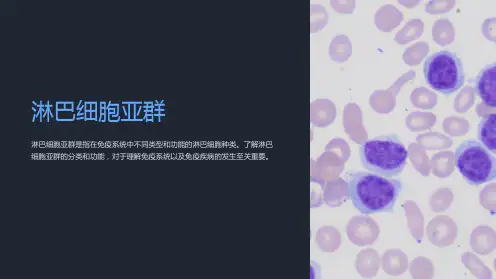

淋巴细胞亚群
- 格式:doc
- 大小:86.50 KB
- 文档页数:4

骨髓淋巴细胞亚群-回复骨髓淋巴细胞亚群是一组在骨髓中产生的淋巴细胞,它们在免疫系统中扮演着重要的角色。
淋巴细胞是免疫系统的重要组成部分,它们通过识别和抵御病原体、维持免疫平衡以及参与免疫记忆等功能,起到保护人体免受感染的作用。
而骨髓淋巴细胞亚群则是淋巴细胞的一种特殊类型,本文将一步一步回答关于骨髓淋巴细胞亚群的疑问。
第一步:什么是骨髓淋巴细胞亚群?骨髓淋巴细胞亚群是骨髓中产生的特殊类型的淋巴细胞。
骨髓是人体内主要的造血器官,其中包括干细胞,它们具有自我复制和分化成各种血细胞的能力。
这种特殊的淋巴细胞亚群在骨髓中形成并发挥功能。
根据它们的功能和特征,可以将骨髓淋巴细胞亚群分为多个亚群。
第二步:骨髓淋巴细胞亚群的分类和特征有哪些?骨髓淋巴细胞亚群通常可以分成B细胞和T细胞两大类。
B细胞主要负责产生和分泌抗体,参与人体的体液免疫反应。
T细胞则以细胞免疫为主,包括细胞毒性T细胞、辅助T细胞和调节性T细胞等。
这些细胞亚群在免疫应答中起到各自的作用。
除了B细胞和T细胞,还有一些其他类型的淋巴细胞亚群,例如自然杀伤细胞(NK细胞)。
NK细胞是一种具有自我识别能力和自发杀伤作用的淋巴细胞,它们通过直接识别和杀伤病原体感染的细胞,发挥着重要的抗病毒和抗肿瘤作用。
第三步:骨髓淋巴细胞亚群在免疫系统中的功能是什么?骨髓淋巴细胞亚群在免疫系统中发挥着多种重要功能。
B细胞通过产生抗体,参与体液免疫反应。
抗体可以与病原体结合,并标记其以供其他免疫细胞吞噬和破坏。
T细胞则通过识别和杀伤病原体感染的细胞,发挥细胞免疫作用。
此外,骨髓淋巴细胞亚群还参与免疫调节。
调节性T细胞可以抑制其他免疫细胞的活性,以维持免疫系统的平衡和自身免疫的稳定。
它们在免疫应答中起到负反馈调节的作用,防止免疫反应过度激活导致自身免疫性疾病的发生。
第四步:骨髓淋巴细胞亚群在疾病中的作用是什么?骨髓淋巴细胞亚群在疾病的发生和发展中起到重要作用。
一方面,它们可以帮助抵御感染,抑制病原体的生长和扩散。

淋巴细胞亚群检测报告怎样看懂?淋巴细胞是一种包括T细胞、B细胞和自然杀伤细胞等多个亚群的白细胞,它们各自具备不同的免疫作用,协同工作来维护机体免疫平衡和抵御外部侵害。
淋巴细胞亚群检测可以帮助医生了解不同亚群的数量和比例,从而判断免疫系统是否受到影响,同时也能够为一些免疫相关疾病的诊断提供重要参考依据。
在本文中,我们将详细介绍淋巴细胞亚群检测报告中的各项指标含义及其正常值范围,希望能够帮助您更好地理解和解读检测结果。
1.淋巴细胞亚群是如何检测淋巴细胞亚群的检测通常采用流式细胞术、荧光素标记技术等方法。
流式细胞术是一种通过测量单个细胞的光学和物理特性来分析淋巴细胞亚群的数量和比例的技术。
通过将淋巴细胞标记上荧光素等物质,然后把标记的淋巴细胞注入流式细胞术仪中,利用激光束照射、散射、荧光及电导等特性检测并分析细胞的类型、数量、活性等参数,从而识别出各类淋巴细胞亚群。
而荧光素标记技术则是一种在淋巴细胞前处理过程中进行标记的技术,该技术可将淋巴细胞分类并标记在表面(例如用荧光标记)后,再使用流式细胞仪来测量并分析淋巴细胞亚群的数量、活性以及分布情况等。
这些检测方法都是无创的、准确度较高、操作简便、结果可靠,已经成为临床上常用的检测手段之一。
1.淋巴细胞亚群检测的临床意义2.1 评估机体免疫功能淋巴细胞是机体免疫系统中最重要的细胞类型之一,在免疫应答中发挥着重要作用。
淋巴细胞亚群检测可以对机体免疫功能进行全面评估,了解机体是否有免疫功能障碍或免疫力下降等问题。
2.2 辅助诊断病情淋巴细胞亚群检测可以帮助医生判断感染性疾病的类型及病情轻重,如通过测定CD4+ T细胞数目,可以确定HIV感染者的病情进展及治疗效果;通过测定CD8+ T细胞数目,可以推测病毒性肝炎等疾病的病情程度。
2.3 指导免疫治疗方案针对某些自身免疫性疾病例如系统性红斑狼疮、类风湿关节炎等,淋巴细胞亚群检测可以帮助医生选择合适的免疫调节治疗方案。

淋巴细胞亚群的临床应用淋巴细胞亚群的临床应用1. 引言本文将介绍淋巴细胞亚群的临床应用。
淋巴细胞是免疫系统中的重要组成部分,根据细胞表面上不同的分子标记,可以将淋巴细胞分为多个亚群。
这些亚群在免疫功能和疾病诊断中扮演着重要角色。
2. 淋巴细胞亚群的划分2.1 Th细胞亚群2.1.1 Th1细胞2.1.2 Th2细胞2.1.3 Th17细胞2.1.4 调节性T细胞(Treg细胞)2.2 CD8+ 细胞2.2.1 抗病毒CD8+ 细胞2.2.2 细胞毒性T淋巴细胞(CTL)3. 淋巴细胞亚群在免疫相关疾病中的应用3.1 自身免疫性疾病3.1.1 类风湿关节炎3.1.2 系统性红斑狼疮3.1.3 1型糖尿病3.2 感染性疾病3.2.1 HIV感染3.2.2 结核病3.2.3 乙型肝炎4. 淋巴细胞亚群在肿瘤免疫治疗中的应用4.1 CAR-T细胞疗法4.2 PD-1抑制剂治疗5. 淋巴细胞亚群在器官移植中的应用5.1 移植排斥反应5.2 移植耐受6. 结论淋巴细胞亚群在临床中扮演着重要角色,对于疾病的诊断和治疗具有重要意义。
进一步研究淋巴细胞亚群的功能和调控机制,将为临床医师提供更精确、个体化的治疗方案。
附件:本文档附带淋巴细胞亚群的常用检测方法和指南。
法律名词及注释:1. 免疫系统:指机体内一系列有关维护机体免受感染和侵害的生理和病理反应的系统。
2. 细胞表面标记:指存在于细胞表面的分子,可用于对细胞进行分类和鉴定。
3. Th细胞:T辅助细胞,是淋巴细胞的一种亚群,具有调节和增强免疫应答的功能。
4. Treg细胞:调节性T细胞,是一种抑制免疫应答的淋巴细胞亚群。
5. CTL:细胞毒性T淋巴细胞,是一种具有杀伤能力的CD8+ 细胞,可识别并杀伤感染细胞或肿瘤细胞。
6. CAR-T细胞疗法:指利用基因工程技术将人工合成的抗原受体(CAR)导入T细胞,增强T细胞对肿瘤细胞的杀伤能力。
7. PD-1抑制剂:一类能够抑制PD-1/PD-L1信号通路的药物,能够增强T细胞的抗肿瘤活性。

淋巴细胞亚群分析六项淋巴细胞亚群分析是淋巴细胞的一种重要的分析技术,它可以用来检测自身免疫功能,特别是对肿瘤的抗肿瘤免疫功能的诊断。
它还可以用来检测某些病毒对淋巴细胞亚群的影响。
淋巴细胞亚群分析六项是淋巴细胞亚群分析的一种基础,它包括六个部分:第一,白细胞计数:它是用来测量淋巴细胞的数目的一种技术,可以用于判断炎症反应的强度。
第二,淋巴细胞比率:它是一种测量淋巴细胞数目和白细胞数目关系的方法,可以用来评估身体对病原体的反应。
第三,B细胞比率:它是一种测量B细胞数量和总淋巴细胞数量比例的方法。
B细胞数量过多或过少可能会引起疾病,所以它是判断是否出现疾病的重要指标。
第四,T细胞比率:它用来测量T细胞数量和总淋巴细胞数量的比例,可用来评估身体免疫力水平,预测是否有发生自身免疫性疾病的风险。
第五,单核细胞比率:它是一种测量单核细胞数量和总淋巴细胞数量的比例的方法,可以用来评估身体免疫力水平,预测某些感染病毒的风险。
第六,前体细胞比率:它是一种测量前体细胞数量和总淋巴细胞数量的比例的方法,可以用来评估身体免疫力水平,预测是否有发生淋巴组织炎的风险。
淋巴细胞亚群分析六项是一种重要的淋巴细胞检测技术,它可以用来诊断某些疾病,特别是抗肿瘤免疫功能的诊断、评估自身免疫水平,以及预测感染病毒的风险。
因此,正确有效地进行淋巴细胞亚群分析六项是非常重要的。
然而,在淋巴细胞亚群分析六项中存在一些技术问题。
首先,淋巴细胞亚群分析六项的结果可能会受到技术因素的影响,比如不同的技术人员和不同的仪器,会对淋巴细胞亚群分析六项的结果产生影响。
其次,由于淋巴细胞的状态会受到各种因素的影响,如营养、运动、疾病、情绪、药物等,因此,淋巴细胞亚群分析六项的结果也会受到这些因素的影响。
为了解决这些技术问题,首先,需要确保技术人员具备正确的技术知识和技能,确保仪器及时维护,确保淋巴细胞亚群分析六项的结果准确可靠;其次,需要提高检测者的生活习惯,如坚持合理饮食,保持适当的运动,注意情绪管理,避免过度服药,等,以免影响淋巴细胞亚群分析六项的结果。

淋巴细胞亚群测定的临床意义
淋巴细胞亚群测定是一种检测体内淋巴细胞数量和比例的方法,通过测定不同亚群的百分比,可以了解到人体免疫系统的状态和功能。
淋巴细胞亚群包括T细胞、B细胞、NK细胞等,它们在人体免疫系统中具有不同的作用。
T细胞是免疫系统中最重要的细胞类型之一,分为CD4+ T细胞
和CD8+ T细胞。
CD4+ T细胞可以激活其他免疫细胞,调节和协调免疫反应,而CD8+ T细胞可以识别并杀死感染人体的细胞。
B细胞主要负责产生抗体,对抗体介导的免疫反应非常重要。
当人体遭受感染时,B细胞会产生与病原体相匹配的抗体,以保护人体免受感染。
NK细胞是一种能够杀死病毒感染和肿瘤细胞的特殊淋巴细胞。
它们对于保持人体健康非常重要,因为它们可以识别和消除异常细胞,防止癌症和病毒感染的发生。
淋巴细胞亚群测定可以帮助医生诊断和治疗一些免疫系统相关
的疾病,如自身免疫性疾病、感染病和癌症等。
通过检测不同亚群的比例,可以了解到免疫系统中的异常情况,为治疗提供有力的依据。
淋巴细胞亚群测定也可以帮助预测某些疾病的预后和疗效,为患者提供更好的治疗方案。
- 1 -。


淋巴细胞亚群临床意义摘要:一、淋巴细胞亚群的基本概念二、淋巴细胞亚群的分型与功能三、淋巴细胞亚群在临床检测中的应用四、淋巴细胞亚群异常与疾病关系五、淋巴细胞亚群的检测方法及其优缺点六、提高淋巴细胞亚群检测的临床意义正文:淋巴细胞亚群在临床检测中具有重要价值,对疾病的诊断、病情监测和治疗评估具有重要作用。
本文将对淋巴细胞亚群的基本概念、分型与功能、临床应用及其在疾病中的异常进行探讨,并分析淋巴细胞亚群检测方法的优缺点,以提高临床对淋巴细胞亚群检测的认识和重视。
一、淋巴细胞亚群的基本概念淋巴细胞亚群是指在淋巴细胞中具有相似表面标志物和功能的细胞群体。
根据表面标志物CD45、CD3、CD4和CD8的表达,淋巴细胞可分为两大类:T细胞(CD3+)和B细胞(CD19+)。
T细胞又可分为辅助性T细胞(CD4+)和细胞毒性T细胞(CD8+),而B细胞则分为成熟B细胞(CD19+)和未成熟B细胞(CD19-)。
二、淋巴细胞亚群的分型与功能1.T细胞:辅助性T细胞(Th)和细胞毒性T细胞(Tc)。
辅助性T细胞负责调节免疫应答,分泌细胞因子,激活B细胞和巨噬细胞等;细胞毒性T细胞具有杀伤病毒感染细胞和肿瘤细胞的能力。
2.B细胞:成熟B细胞和未成熟B细胞。
成熟B细胞分泌抗体,参与体液免疫;未成熟B细胞在免疫应答过程中发育成熟。
三、淋巴细胞亚群在临床检测中的应用1.外周血淋巴细胞亚群比例的检测:通过流式细胞术检测外周血淋巴细胞亚群的比例,了解机体免疫状态,评估免疫功能异常。
2.淋巴细胞亚群受体基因表达检测:实时荧光定量PCR技术检测淋巴细胞亚群受体基因表达水平,指导免疫治疗方案的制定。
3.淋巴细胞亚群免疫功能检测:细胞毒试验、酶联免疫吸附试验等方法检测淋巴细胞亚群的免疫功能,评估机体免疫应答能力。
四、淋巴细胞亚群异常与疾病关系1.淋巴细胞亚群数量异常:如淋巴细胞减少可见于病毒感染、免疫缺陷病等;淋巴细胞增多可见于急性感染、白血病等。

淋巴细胞亚群正常范围
淋巴细胞亚群是指淋巴细胞的不同类型,包括T细胞、B细胞和自然杀伤细胞。
它们在免疫系统中起着重要作用,帮助身体对抗感染和疾病。
正常范围会因年龄、性别和实验室方法的不同而有所变化。
一般来说,以下是淋巴细胞亚群的正常范围:
1. CD3+T细胞,在成年人中,CD3+T细胞的正常范围约为60%至85%。
2. CD4+T细胞,CD4+T细胞在成年人中的正常范围约为410至1590细胞/μL。
3. CD8+T细胞,CD8+T细胞在成年人中的正常范围约为180至1000细胞/μL。
4. B细胞,在成年人中,B细胞的正常范围约为5%至25%。
5. 自然杀伤细胞,在成年人中,自然杀伤细胞的正常范围约为90至500细胞/μL。
需要注意的是,这些数值仅供参考,实际正常范围可能会因个体差异而有所不同。
如果有任何疑问,建议咨询专业医生进行详细的检查和解释。

淋巴细胞亚群流式细胞学检查
淋巴细胞亚群流式细胞学检查是一种检测淋巴细胞亚群的方法。
淋巴细胞是免疫系统的重要组成部分,包括T细胞、B细胞和自然杀伤细胞等亚群。
这些亚群在免疫应答中发挥着不同的作用。
流式细胞学是一种可靠的检测淋巴细胞亚群的方法。
在流式细胞学中,通过利用细胞表面分子的不同表达,将淋巴细胞分成不同的亚群。
利用荧光标记的抗体,可以快速、准确地检测出特定亚群的淋巴细胞。
淋巴细胞亚群流式细胞学检查可以用于评估免疫功能、诊断免疫相关疾病、监测疾病治疗效果等方面。
常见的淋巴细胞亚群包括CD4+ T细胞、CD8+ T细胞、B细胞、NK细胞等。
其中,CD4+ T细胞是免疫系统的主要调节细胞,其数量和功能状态对于正常免疫系统的维持至关重要。
总之,淋巴细胞亚群流式细胞学检查是一种重要的免疫学检查方法,可以为临床诊断和治疗提供可靠的参考依据。
- 1 -。
淋巴细胞亚群结果判读
淋巴细胞亚群结果是指血液中淋巴细胞的不同类型的百分比或
绝对数。
淋巴细胞亚群包括T淋巴细胞、B淋巴细胞、NK细胞等。
通过对这些细胞亚群的检测和分析,可以更好地了解免疫系统的功
能状态和疾病的发展情况。
对于淋巴细胞亚群结果的判读,需要综合考虑各个细胞亚群的
百分比或绝对数,并结合临床病史、症状以及其他相关检查结果进
行综合分析。
一般来说,正常情况下,T淋巴细胞占淋巴细胞总数
的70-85%,B淋巴细胞占5-15%,NK细胞占5-20%。
如果某个淋巴
细胞亚群的比例高于或低于正常范围,可能意味着免疫系统出现异常。
具体的判读结果还需要结合临床情况来分析,比如T淋巴细胞
亚群的异常增多可能与病毒感染、免疫功能异常、恶性肿瘤等有关;B淋巴细胞亚群的异常增多可能与慢性感染、自身免疫性疾病等有关;NK细胞亚群的异常增多可能与病毒感染、恶性肿瘤等有关。
总之,淋巴细胞亚群结果的判读需要综合分析,不能单一看待
某一个细胞亚群的异常情况,而是需要结合临床资料进行综合判断,最终由临床医生根据具体情况进行诊断和治疗。
淋巴细胞亚群计数淋巴细胞是人体免疫系统中的重要组成部分,主要负责免疫应答和维持免疫平衡。
根据表面标记分子的不同,淋巴细胞可以分为多个亚群,如T细胞、B细胞和自然杀伤细胞等。
这些淋巴细胞亚群在免疫应答中扮演着不同的角色,对于人体的健康至关重要。
T细胞是一类重要的淋巴细胞亚群,它们通过表面上的T细胞受体(TCR)与抗原结合,参与调节和介导免疫应答。
根据表面标记分子CD4和CD8的不同组合,T细胞可以进一步分为辅助T细胞(Th细胞)和细胞毒性T细胞(Tc细胞)。
Th细胞主要负责调节和协调免疫应答,可以分为Th1细胞、Th2细胞、Th17细胞和调节性T细胞(Treg细胞)等。
这些不同的亚群在免疫应答中发挥着不同的作用,如Th1细胞参与细胞免疫应答,Th2细胞参与体液免疫应答,Th17细胞参与炎症反应调节,而Treg细胞则起到免疫耐受和免疫调节的作用。
B细胞是另一类重要的淋巴细胞亚群,它们通过表面上的B细胞受体(BCR)与抗原结合,产生抗体并参与体液免疫应答。
B细胞可以进一步分化为记忆B细胞和浆细胞。
记忆B细胞可以长期存留于体内,一旦再次遇到相同抗原则能够更快速、更有效地产生抗体,从而提供长期免疫保护。
而浆细胞则是B细胞分化的终末阶段,它们能够大量产生抗体,以中和病原体、促进炎症反应等方式参与免疫应答。
除了T细胞和B细胞,还有一类重要的淋巴细胞亚群被称为自然杀伤细胞(NK细胞)。
NK细胞具有自身识别和非特异性杀伤作用,主要参与抗病毒、抗肿瘤和调节免疫应答等。
NK细胞通过表面上的激活受体和抑制受体对目标细胞进行识别和调控,从而发挥免疫监视和杀伤作用。
淋巴细胞亚群计数是评估人体免疫功能的重要指标之一。
通过测定不同淋巴细胞亚群的细胞数量,可以了解免疫系统的状态和功能。
在临床实践中,常用的方法包括流式细胞术和免疫荧光染色等。
通过对淋巴细胞亚群计数的观察和分析,可以判断免疫功能是否正常,是否存在免疫缺陷或免疫异常等情况。
临床淋巴细胞亚群及检测意义淋巴细胞是构成免疫系统的主要细胞类别,占外周血白细胞总数的20%-45%;淋巴细胞亚群分类可将淋巴细胞分为T、 B、NK细胞等。
T 细胞主要参与细胞免疫,表达 CD3 抗原,T 细胞又包括辅助 T 细胞(Th)和抑制 T 细胞(Ts),它们分别表达CD4 和 CD8。
CD4+T 细胞:辅助性 T 细胞(help T cell, TH)包括TH 1 和 TH 2 细胞。
TH 1 细胞与抗原接触后,可通过释放 IL-2、IFN-α、TFN-β等因子,引起炎症反应或迟发型超敏反应,TH1 细胞又称为炎性 T 细胞;TH2 细胞可通过释放 IL-4、5、6、10 等因子,诱导 B 细胞增殖、分化、分泌抗体, 引起体液免疫应答。
外周血中 CD4 淋巴细胞计数在 500 以上则够用,350-500 免疫力偏低,200-350 时需要警惕。
CD8+T 细胞:主要包括细胞毒 T 细胞(Tc 或 CTL)和抑制性 T 细胞(Ts)。
Tc 细胞为细胞免疫效应细胞,经抗原致敏后,可特异性杀死带致敏抗原的靶细胞。
抑制性 T 细胞(Ts,其存在尚有争议)具有抑制体液免疫和细胞免疫的功能,通过分泌抑制性细胞因子和 IFN-γ,抑制体液免疫和细胞免疫。
B 细胞主要参与体液免疫,表达 CD19 抗原;NK 细胞表达 CD16 和/或 CD56,在机体中不依赖抗原刺激自发地发挥细胞毒效应。
T淋巴细胞检测的临床意义检测细项结果临床意义总T细胞CD3+ 60-80%降低提示免疫功能减弱,易发生机会性感染。
升高提示免疫反应性增强,易发超敏反应,也见于自身免疫病。
辅助/诱导T 细胞(CD3+CD4 +)35-55%降低常见于病毒性感染,艾滋病、细胞免疫功能低下、恶性肿瘤、严重创伤和手术。
升高常见于细菌性感染,细胞免疫反应过强,免疫增强剂治疗。
抑制/细胞毒T细胞(CD3+CD8+)20-30%降低提示免疫功能减弱,易发生机会性感染。
淋巴细胞亚群的解读
淋巴细胞亚群属于T淋巴细胞亚细胞群,这些数值低说明免疫力较低,应该加强锻炼,增强身体素质,如果较为严重的话,应服用升高白细胞的药物。
T淋巴细胞亚群主管细胞免疫,具有抵抗病毒和调节免疫系统功能的作用。
其细胞功能取决于T淋巴细胞总值(CD3+)及其亚群(CD4+、CD8+)的相对组成。
正常情况下,亚群间互相拮抗达到平衡;当免疫失衡,细胞数及比值发生紊乱,则易引发疾病。
CD4+是诱导和辅助,CD8+是抑制和毒杀;CD4+、CD8+的变化并不同步,互为对立和协调;CD3+与CD4+步调基本相同,
CD4+/CD8+比值来判断内部是否紊乱。
T细胞主要包括T辅助细胞(Th)和T抑制细胞(Ts)细胞亚群。
CD3+细胞代表外周血中总的成熟T细胞,理论上应约等于CD4+细胞和CD8+细胞的总和,但往往出现CD4+加CD8+细胞之和大于CD3+,这是因为CD4+细胞包括CD3+/CD4+细胞(真正Th细胞)和CD3-CD4+细胞(非Ts细胞),而后者包括CD3-CD8+CD16+56+细胞(一部分NK细胞)和CD3-CD8+CD16+56-(未知细胞)。
由此可见,真正的TH细胞是CD3+CD4+细胞,真正Ts细胞是CD3+CD8+细胞。
尤其当患者NK细胞明显增加时,会使CD4细胞和CD8细胞的总和远大于CD3+细胞,因此,用三色荧光标记才能分析真正的辅助性T细胞和抑制性T细胞。
首先在淋巴细胞中识别出CD3细胞,然后在CD3细胞中再区分CD4+和CD8+细胞。
NK细胞的表面无T细胞和B细胞表面标志,但有CD16和CD56等标志,用CD16+56抗体能鉴定出NK细胞(一定是CD3阴性),CD3-CD16+56+细胞才是真正的NK细胞。
根据是否表达CD8,又可将NK细胞分为CD3-CD8+CD16+56+细胞(所占比例小,不影响CD8比例)和CD3-CD8-CD16+56+细胞(主要成分)。
B细胞的表面标志是CD19,理论上CD3-CD19+细胞才是真正的B淋巴细胞。
但CD3+CD19+细胞很少,可忽略不计,所以CD19+细胞就是B淋巴细胞。
在抗肿瘤效应中,CD4和CD8分别是T淋巴细胞的辅助/诱导细胞亚群与抑制/细胞毒细胞亚群,CD4细胞的主要功能是通过其分泌的淋巴因子,增强和扩大免疫应答过程,辅助诱导其它免疫细胞如杀伤性T细胞,B细胞等共同发挥抗肿瘤作用,CD4细胞的减少,导致免疫功能低下。
CD4/CD8比值是重要的免疫状态监测指标,其比例的降低与免疫系统损害的程度相关。
CD4降低见于恶性肿瘤、遗传性免疫缺陷症、艾滋病、应用免疫抑制剂者;CD8降低见于自身免疫性疾病或变态反应性疾病;CD4/CD8比值升高见于恶性肿瘤、自身免疫性疾病、变态反应、病毒感染等;CD4/CD8比值降低见于艾滋病(常小于。
监测器官移植排斥反应时,CD4/CD8比值升高预示可能发生排斥反应。
淋巴细胞担负着免疫的主要功能。
淋巴细胞亚群的测定有助于了解机体免疫状况及一些疾病的监测。
利用各种单克隆抗体与淋巴细胞表面的抗原结合,再配合多色荧光染料,通过流式细胞仪检测分析即可以把各种不同功能的淋巴亚群区分开来,进而得到各亚群的相对比例。
最常检测的亚群包括T细胞(CD3)、B细胞(CD19)、NK细胞(CD16+56)、辅助性T细胞(CD3+CD4+)和抑制性T细胞(CD3+CD8+)等等。
(1) 应用CD3/CD19区分T淋巴细胞和B淋巴细胞
CD3是T细胞的特异性抗原,CD19则用来识别B细胞.因此应用CD3/CD19双标试剂即可以区分和鉴定T淋巴细胞和B淋巴细胞亚群;CD3、CD19阳性表达为独立的阳性细胞群体。
如出现双阳性细胞均为假象。
这样就可不用同型对照来设定阴性或阳性界线。
此外,此检测还会出现双阴性群体,这些都是NK细胞,这些细胞也提供了双阴性群体的对照。
(2) 应用CD3/CD4来鉴定CD4+T细胞
首先用CD3来区分全部T细胞.而CD3/CD4双阳性细胞为真正的辅助/诱导性T细胞,这是HIV病毒感染的主要对象;CD3-/CD4+细胞群是由单核细胞组成,这些细胞相对于CD4+和T细胞来说弱表达CD4,在光散射参数的位置分布也较广。
所以CD3/CD4抗体组合能够完全把CD4阳性辅助/诱导性T细胞区分开。
另外,应用适当的双色组合如CD4与CD29,CD4与CD45RA,也可以测定T辅助细胞的的亚群。
如CD4+2H4(CD 45RA)+细胞是Ts的诱导细胞;CD4+ 4B4 (CD29)+细胞Th的诱导细胞。
同理,•利用CD8+CD45RA和CD8+CD29+ S6F1可测定T抑制细胞的亚群。
T辅助细胞还可分成Th1、Th2两个亚群,同时标记细胞内细胞因子IFN-γ和IL-4,可区分Th1细胞(CD4+/IFN-γ+)和Th2细胞(CD4+/IL-4+)。
(3)应用CD3/CD8鉴定CD8+T淋巴细胞
CD8的表达不只限于细胞毒性T细胞,此抗原在部分的NK细胞上也能检测到。
所以利用CD3抗体才能把该细胞亚群分开。
若采用三色测定可给出更为准确的各亚群的情况:如真正的T辅助细胞应是CD3+ CD4+CD8-,真正的T抑制细胞应是CD3+CD4- CD8+,单标CD8+细胞中不仅有T抑制细胞,还含有30%左右的NK细胞;而CD3+CD4-CD8-细胞群是γδT细胞,此类细胞与感染有关.CD3+CD4+ CD8-细胞+CD3+CD4-CD8+细胞+CD3+CD4-CD8-细胞
+CD3+CD4+CD8+细胞=CD3+细胞。
(4) 自然杀伤细胞(NK)的检测
①CD16(FcRⅢ)表达于大多数NK细胞上,但也表达于中性粒细胞,此抗原NK细胞的表达比较弱,并在NK 细胞活化时丢失;②CD56表达于大多数NK细胞上,也表达于一些T淋巴细胞,与CD3联合使用可以区分CD3+/CD56+T淋巴细胞和CD3-/CD56+NK细胞。
③联合使用3种抗体最完全地鉴定所有的NK细胞。
NK细胞或表达CD16,或表达CD56,但它们不表达CD3。
CD16和CD56联合使用,根据荧光强度可将NK细胞从双阴性细胞中区分出来。
这样运用该试剂组合,NK细胞可形成独立的群体与其它细胞相区分。
图1 流式分析细胞亚群
外周血是临床检验中的重要标本。
FCM分析外周白细胞的主要目的是了解各种白细胞的数目与分群情况。
以下给出常用细胞亚群的正常范围供参考,请注意同一CD中有多种克隆的McAb,同一CD中不同McAb•所测出的数值不同,每个实验室应测定自己实验室的正常数值:
表1 人外周血各细胞亚群表面抗原和流式检测的正常参考值
细胞表面抗原细胞名称正常参考值(%)
T细胞抗原
CD2总T细胞
成熟T细胞
辅助/诱导性细胞亚群
细胞(B细胞亚群)
细胞/细胞毒性细胞亚群
细胞受体共刺激分子
CD8+/CD28+细胞毒性T细胞
抑制性细胞
静止T细胞
B细胞抗原
CD19全部B细胞
全部B细胞
NK细胞抗原
CD3-/CD(16+56)+NK细胞。